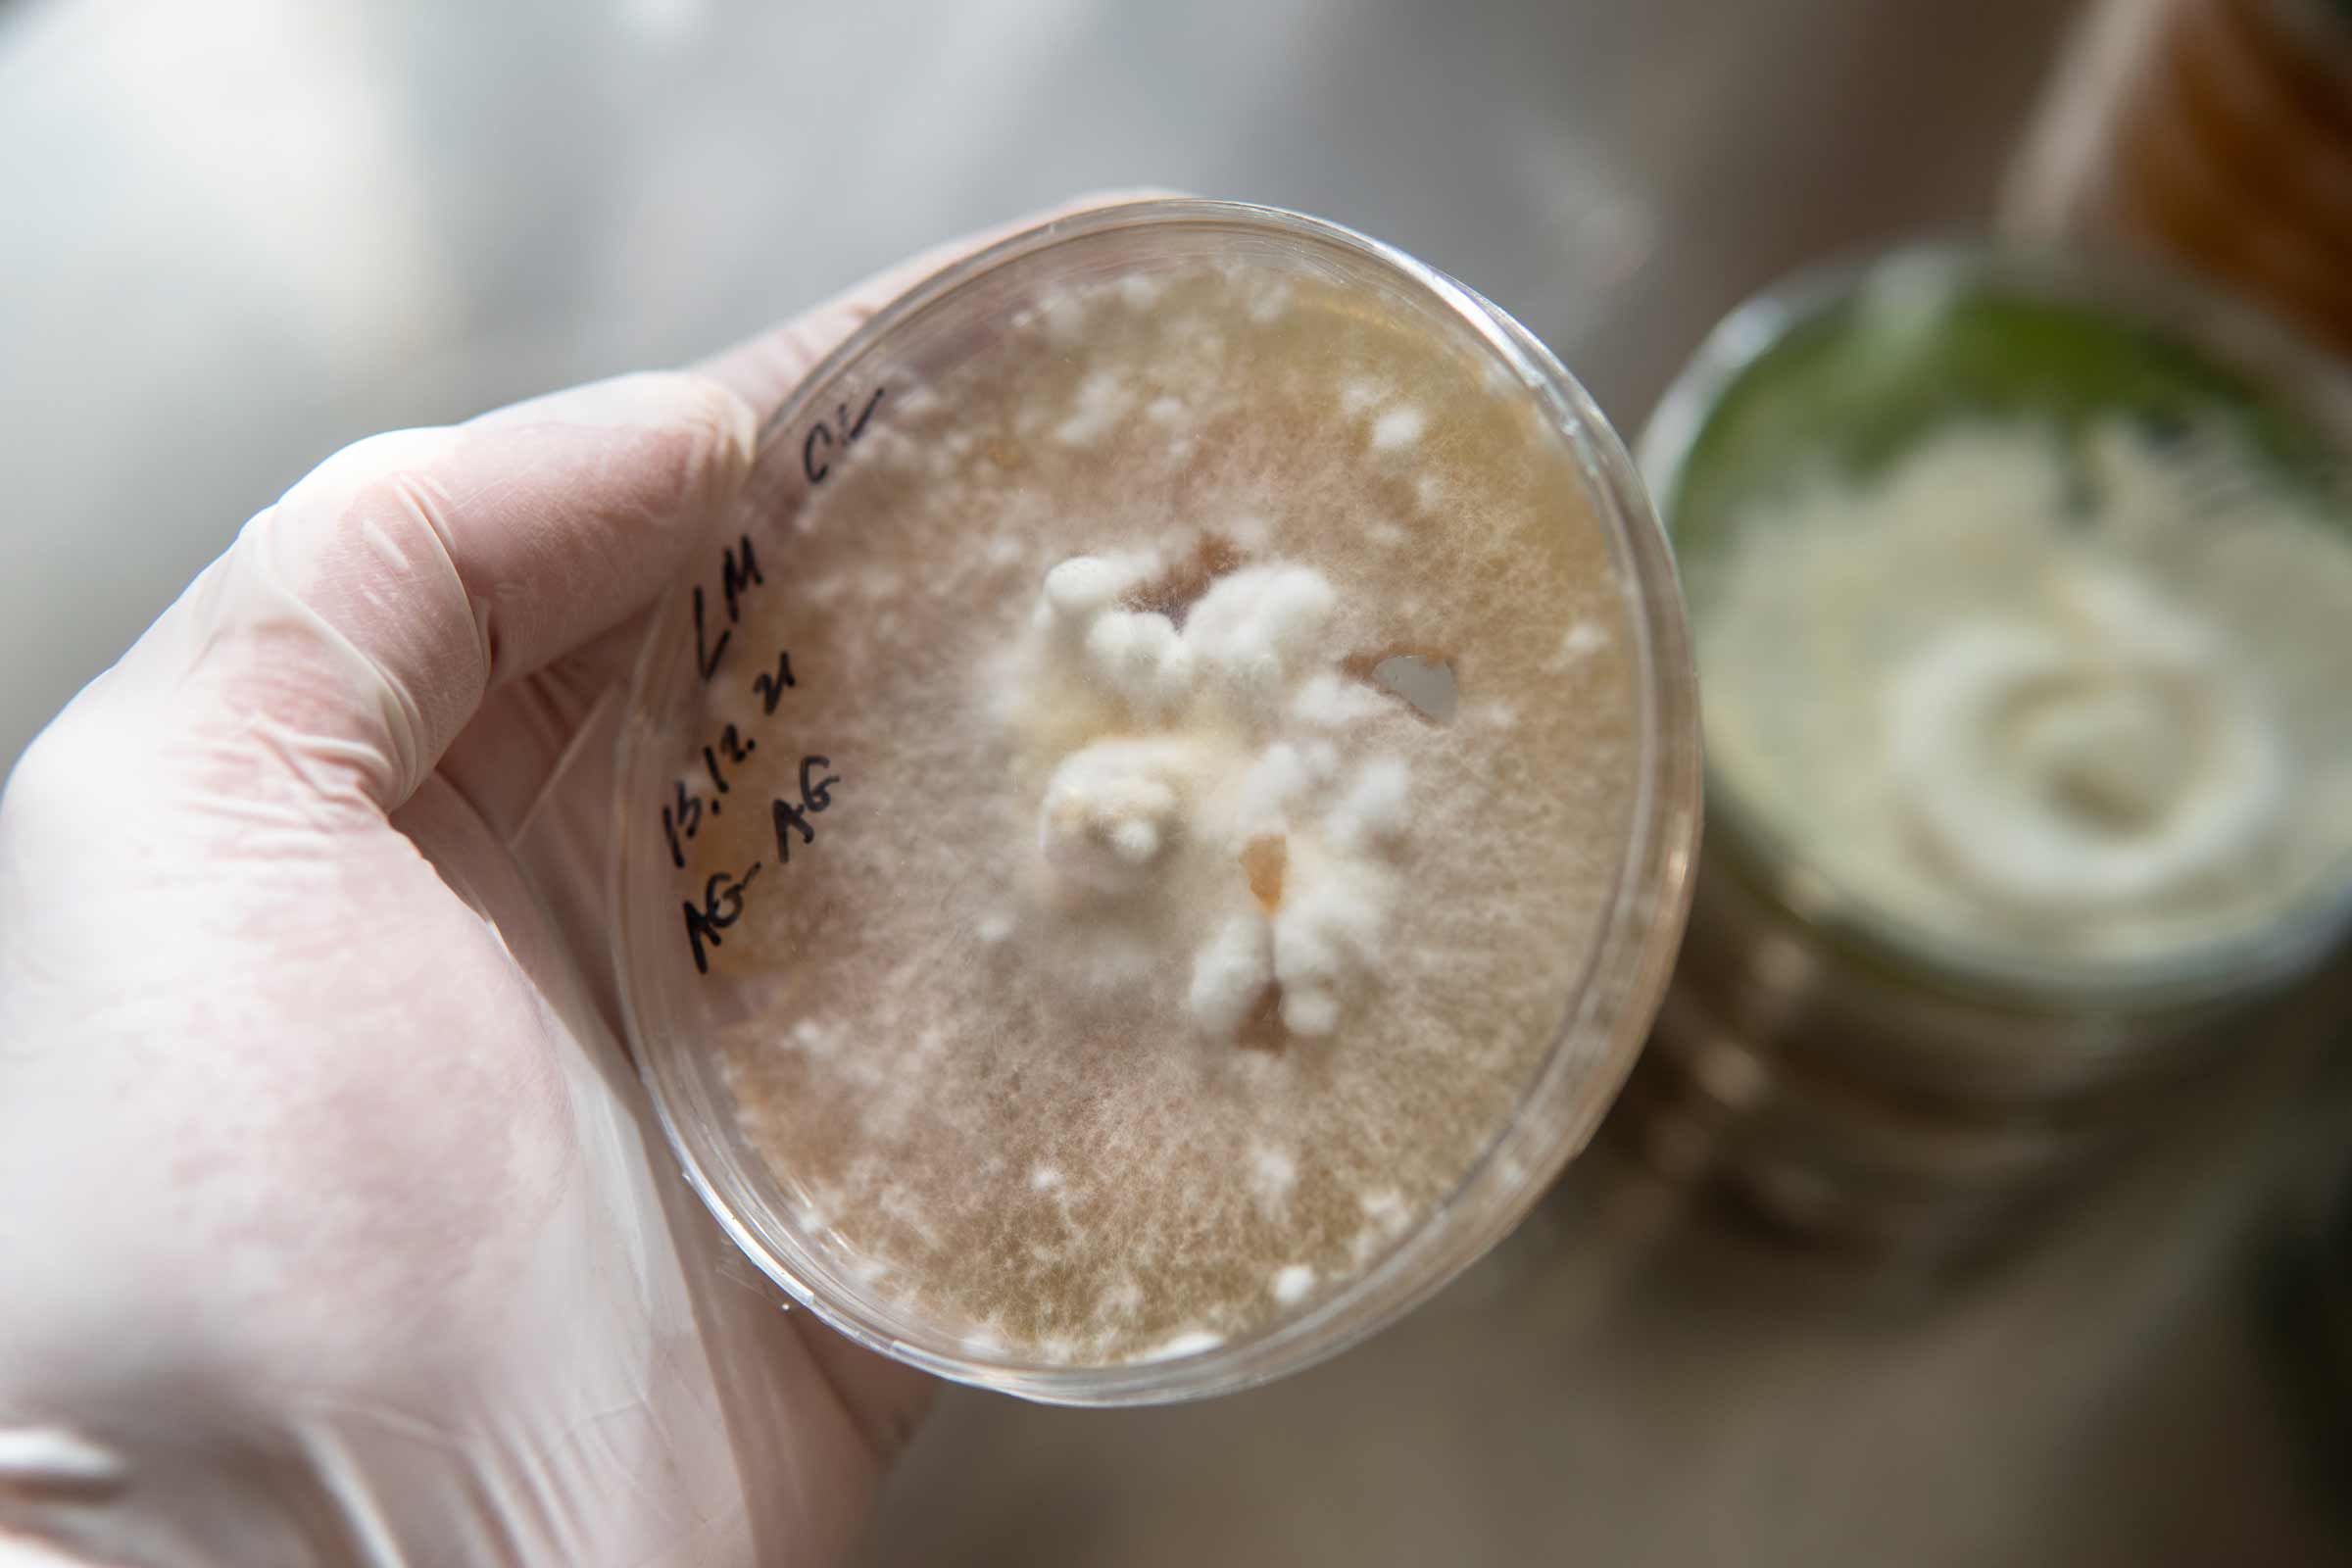

Low stock
Organic Lion's Mane Mushroom, 90 Capsules
Our signature certified organic Lion's Mane mushrooms. Non-GMO, lab-grown and significantly stronger than wild grown mushrooms or standardized extracts. Cooked twice to 125°C.*
Pairs well with

DNA Match Spot Testing

58% polysaccharides (variable/batch)

50% beta-glucan's (variable/batch)

Organic Lion's Mane Mushroom, 90 Capsules
$23.95
🇺🇸 100% Grown & Made in the USA
Brain Forza® Organic Lion's Mane Mushroom
Brain Forza® Lion’s Mane Mushroom is a premium functional mushroom formulated to support cognitive health, focus, and mental clarity for daily performance.*
-
Mushrooms are Grown & Made in the USA
-
Typically 1.5-3x Stronger Than Extracts
-
Made From All Parts of the Mushroom
-
Pure High-Potency Lion's Mane Mushroom
-
USDA Certified Organic, Non-GMO & Gluten-Free
🚫 No rice or oats - our mushrooms are grown on one of the USA's most ancient superfoods - organic White Milo (Sorghum)
Organic Lion's Mane Mushroom
What does it do?
Brain Forza® Lion's Mane Mushroom may support the following:

Lion's Mane Mushroom
Lion’s Mane (Hericium erinaceus) is a functional mushroom long used in Traditional Chinese and Japanese herbal systems. Known for its distinctive cascading appearance, it belongs to the tooth fungus group and is sometimes called Bearded Tooth or Pom Pom Mushroom.
Historically consumed as both food and tonic, Lion’s Mane was once reserved for royalty and remains a staple in Chinese vegetarian cuisine, often used as a substitute for meat due to its dense texture.
Today, Lion’s Mane is increasingly studied for its potential to support cognitive function, mood, and nervous system health. Its unique structure contains naturally occurring compounds now widely researched in the context of brain and nerve support.*
Lions Mane Mushroom Highlights
The Ingredients
1,500 mg
Lion’s Mane Mushroom is a natural powerhouse known for supporting cognitive function, focus, and mental clarity. Revered for its unique ability to promote overall vitality, it’s a go-to for those seeking enhanced mental performance and a sense of balance in their daily lives.*
1,500 mg
Supplement Facts
Other Ingredients: Vegetarian capsules (pullulan), Organic sorghum ≤5%
Suggested Use: Take one capsule three times daily with water or, three capsules once daily with water.
Allergens: Manufactured in a facility that processes wheat, gluten, soy, milk, egg, shellfish and tree nut ingredients.
Warning: This product is for adults only. Always contact a physician if you are taking medication, have a medical condition, or are pregnant or nursing. Keep out of reach of children.
FAQs
What part of the mushroom do you use?
We use a full-spectrum blend that includes both fruiting body and mycelium, grown in the USA. This provides a complete nutrient profile and active compound range.
Is your Lion’s Mane certified organic?
Yes, the raw materials are certified USDA Organic. Our mushrooms are cultivated without pesticides, herbicides, or synthetic inputs.
How is your Lion’s Mane grown and made?
Our Lion’s Mane is grown, dried, and processed in the USA, under controlled indoor conditions using organic feedstock and filtered air systems. Nothing is imported or extracted.
What does Lion’s Mane help with?
Lion’s Mane is used to support memory, mood, and cognitive function, as well as healthy nervous system performance. It’s often taken to promote mental clarity, focus, and emotional well-being.*
Is this safe to take daily?
Yes, Lion’s Mane is commonly used as a daily supplement. Our formula is free of caffeine, fillers, and stimulants—designed for daily cognitive and mood support.*
Does it contain any stimulants or caffeine?
No. Our Lion’s Mane formula is 100% stimulant-free. It supports focus and clarity without caffeine or other central nervous system stimulants.
What is the suggested use?
Take 1 capsule daily, with or without food. For stronger support, you may take up to 2 capsules per day.